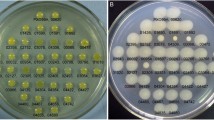

Abstract
Rice blast caused by Magnaporthe oryzae severely impacts global rice yield stability. The rice endophyte Streptomyces sporocinereus OsiSh-2, with strong antagonistic activity towards M. oryzae, has been reported in our previous study. To decipher the model of the antagonistic action of OsiSh-2 towards M. oryzae, we compared the iron-capturing abilities of these two strains. The cultivation of OsiSh-2 and a M. oryzae strain under iron-rich and iron-starved conditions showed that M. oryzae depended more on iron supplementation for growth and development than did OsiSh-2. Genomic analysis of the S. sporocinereus and M. oryzae species strains revealed that they might possess different iron acquisition strategies. The actinobacterium OsiSh-2 is likely to favor siderophore utilization compared to the fungus M. oryzae. In addition, protein annotations found that OsiSh-2 contains the highest number of the siderophore biosynthetic gene clusters among the 13 endophytic actinomycete strains and 13 antifungal actinomycete strains that we compared, indicating the prominent siderophore production potential of OsiSh-2. Additionally, we verified that OsiSh-2 could excrete considerably more siderophores than Guy11 under iron-restricted conditions and displayed greater Fe3+-reducing activity during iron-supplemental conditions. Measurements of the iron mobilization between the antagonistic OsiSh-2 and Guy11 showed that the iron concentration is higher around OsiSh-2 than around Guy11. In addition, adding iron near OsiSh-2 could decrease the antagonism of OsiSh-2 towards Guy11. Our study revealed that the antagonistic capacity displayed by OsiSh-2 towards M. oryzae was related to the competition for iron. The highly efficient iron acquisition system of OsiSh-2 may offer valuable insight for the biocontrol of rice blast.
Similar content being viewed by others
Avoid common mistakes on your manuscript.
Introduction
Rice contributes approximately 30% of the global food supply [1]. However, its production suffers severely from crop diseases, especially rice blast, which has spread worldwide. The causative agent of rice blast is a filamentous ascomycete fungus, Magnaporthe oryzae. Recently, this pathogen emerged as an agronomically important microorganism for investigating fungus-caused plant diseases [2].
The biological control of rice blast has received considerable attention. Compared to traditional strategies, it has increased the durability of disease resistance while sustaining environmental friendly conditions [3]. The antagonistic microorganism that is commonly isolated from the plant rhizosphere and soil is one of the most reported biocontrol agents for blast suppression [4]. Nevertheless, recent literatures suggest that endophytes, microbes that cooperatively inhabit plants, could be novel promising candidates for biocontrol agents [5].
Analogous to the gut microflora in humans, endophytes inside plants exhibit multiple functions in host health, such as boosting plant growth and protecting the host from pathogen invasion [6]. For example, the rice endophyte Harpophora oryzae plays a useful role in restricting rice blast [7], and the endophyte Bacillus subtilis var. amyloliquefaciens FZB24 contributes to late blight resistance and promotes grain yield [8]. It is worth noting that endophytic actinomycetes display high potential for disease control since they are capable of producing secondary metabolites with diverse biological activities [9]. For instance, endophytic actinomycete strains could improve plant growth and suppress the pathogen Pythium aphanidermatum on cucumbers [10]. Additionally, the endophytic Streptomyces sp. S96 could notably reduce fusarium wilt disease on banana [11]. However, the modes of action of the endophytic antagonists against fungal pathogens are still unclear. Initially, it is believed that actinomycetes could secrete antibiotics that result in the antagonism. However, in many cases, the competitive acquisition of nutrients by actinomycetes might induce antagonism as well [12].
Iron is an essential nutrient involved in primary metabolic processes, including respiration, photosynthesis, and DNA replication, for most organisms [13]. However, iron is not always bioavailable for organisms due to its poor solubility in the form of ferric iron (Fe3+), which exists predominantly in aerobic environments [14]. Consequently, microbes utilize various systems to acquire iron from the environment. A common strategy is the synthesis and secretion of siderophores, a kind of small molecular organic compounds with a high affinity for ferric iron. The concept is to use siderophores to sequester extracellular iron, especially when iron availability is limited. Siderophores from different microbes vary in their ability to sequester iron. Commonly, the iron affinities of fungal siderophores are lower than those of bacterial siderophores [15, 16]. Given the indispensable role of iron, this difference might modulate the microbial communities in a specific environment. For example, one actinomycete, Amycolatopsis sp. AA4, could inhibit the development of adjacent colonies of Streptomyces coelicolor by siderophore piracy [17]. Siderophore-mediated iron competition between the soil-borne pathogens and their antagonistic microorganisms was reported to be helpful in disease suppression [18]. Many microbes, e.g., Schizosaccharomyces pombe and Mycobacterium paratuberculosis, also encode enzymes that reduce Fe3+ into the more soluble ferrous form (Fe2+) [19, 20]. Currently, research on the interaction between M. oryzae and the endophytic antagonists involved in iron acquisition has rarely been reported.
In our previous study, we obtained a rice endophytic actinobacterium, Streptomyces sporocinereus OsiSh-2, which exhibited remarkable antagonistic activity against rice blast under laboratory and field conditions [5]. Understanding the mechanisms underlying the resistance of this plant endophyte to pathogenic fungi will be essential for its efficient application in crop protection. In the present study, to confirm the role of iron competition in rice blast inhibition, we evaluated the growth and development of M. oryzae Guy11 and S. sporocinereus OsiSh-2 under different states of iron supplementation. We compared the iron-acquiring ability of Guy11 and OsiSh-2 through genomic analysis, Fe3+-reducing activity measurement and siderophore production detection. In addition, we assessed the iron competition between these two strains by determination of the iron concentration in culture media. Moreover, the impact of iron on the antagonistic interaction was evaluated by a dual cultural assay.
Methods
Microorganism Strains and Growth Media
The S. sporocinereus strain OsiSh-2 was obtained as previously reported [5]. The M. oryzae strain Guy11 was provided by the Hunan Academy of Agricultural Sciences (Changsha, China). Strains were grown at 30 °C in potato dextrose agar (PDA) media to observe their growth and to conduct the iron competition assay. For siderophore production, the strains were cultivated in media containing 0.5% peptone and 0.1% yeast extract, pH 7.0 [21]. The effect of Fe sources on strain growth was observed by supplementing the culture media with 10, 100, and 300 μM FeCl3 or with 10, 100, 200, and 300 μM 2,2′-dipyridyl [22].
Siderophore Production and Fe3+-Reducing Activity Assay
The OsiSh-2 and Guy11 strains were inoculated in siderophore-producing media supplemented with 10 μM FeCl3 or 2,2′-dipyridyl at 30 °C and 170 rpm for 1 week. The growth curves of the strains were determined as described previously [5]. The fermentation broth was centrifuged at 7378×g for 2 min, and the siderophore activity in supernatant extracts was quantified by CAS solution assay [23]. The Fe3+-reducing activity was determined using a ferrozine assay [24].
Comparative Genome Analyses
Genome Annotations of Selected S. sporocinereus and M. oryzae Strains
Using WebMGA (http://weizhonglab.ucsd.edu/), the protein function was organized in multiple levels: COG (Clusters of Orthologous Groups) analysis for actinomycetes, KOG (euKaryotic Ortholog Groups) analysis for M. oryzae, and KEGG pathway analysis for all investigated genes [25]. The GO (Gene Ontology) annotations of the proteins were obtained from AgBase 2.00 (http://agbase.msstate.edu/cgi-bin/tools/GOanna.cgi) [26].
Secondary metabolite biosynthetic gene clusters were predicted using antiSMASH (v.3.0) with the ClusterFinder algorithm for the border prediction (https://antismash.secondarymetabolites.org/) [27].
Analysis of Iron Acquisition-Related Genes
Ferric reductase, peroxidase, catalase, and siderophore biosynthetic and transport genes were collected and statistically analyzed based on genome annotations. For the homologous classification, 125 ferric reductase proteins belonging to different homologous families (FRE, AIM, CFL, FRP, FET, FTR, ARN, ATF, and MAC) were collected to construct a ferric reductase database through the makeblastdb program. Based on this database and the BLASTP program, ferric reductases from the investigated strains were classified into a specific protein family if a BLASTP search resulted in a global identity of more than 30% and coverage of more than 50% [28].
Estimation of Iron Mobilization Between OsiSh-2 and Guy11 in Cultivated Media
The culture dish was marked in a straight and equidistant manner to create seven blocks, which were defined as points 1 to 7, respectively, i.e., the location of point 4 was in the dish center. The Guy11 and OsiSh-2 strains were inoculated at points 2 and 6, respectively. After cocultivation for 5 days, the medium at each point was collected with the elimination of the microbial colonies. These samples were introduced into a Teflon vessel. After 1 ml of concentrated nitric acid was added, a heating program of 300 W for 2 min and ventilation for 1 h proceeded. The digested solution was then transferred to a tube, and the volume was brought to 10 ml with deionized water. The concentration of iron in this aqueous solution was determined using a UV spectrophotometer (UV-1800, SHIMADZU Corporation, Japan) according to the phenanthroline method [29].
Results
Growth and Development of S. sporocinereus OsiSh-2 and M. oryzae Guy11 Under Iron-Sufficient and Iron-Deprived Conditions
To investigate the effect of iron resources on the growth and development of the pathogen and its antagonist, we inoculated M. oryzae Guy11 and S. sporocinereus OsiSh-2 under iron-sufficient and iron-deprived conditions, i.e., PDA medium supplied with different concentrations of FeCl3 (10–300 μM) and of the iron-chelating compound 2,2′-dipyridyl (10–300 μM), respectively. On FeCl3-rich medium, Guy11 displayed stronger mycelia growth and sporulation than the control (Fig. 1). However, fungal growth was obviously reduced in a seriously iron-deficient environment (> 200 μM 2,2′-dipyridyl) and was completely inhibited at 300 μM 2,2′-dipyridyl (Fig. 1). An exception was found on media with a low concentration of 2,2′-dipyridyl (10 μM): Guy11 showed a small degree of promotion of colony growth and conidial generation compared with the control (Fig. 1). It was reported that a minor amount of 2,2′-dipyridyl could increase the growth rate of some plant tissues due to induced cell elongation [30, 31]. Whether this is the same reason for our observation deserves further study.
In contrast to Guy11, almost no marked variation in the growth of the OsiSh-2 colony was observed following the addition of low and high concentrations of FeCl3 (Fig. 1). Even though OsiSh-2 could grow in the iron starvation environment, a delayed appearance of hyphae was observed under a severely iron-deficient condition (induced with 300 μM 2,2′-dipyridyl). This finding was consistent with the result previously reported [17].
Bioinformatics Analyses of Iron Uptake Systems Used by M. oryzae and S. sporocinereus
Given the significant differences in the dependency on iron resources between Guy11 and OsiSh-2, we hypothesize that these two antagonistic microbes contain different iron acquisition systems. Only two S. sporocinereus strains (including OsiSh-2) and three M. oryzae strains with genome sequencing and protein annotations were obtained from the GenBank database (https://www.ncbi.nlm.nih.g-ov/genome/: S. sporocinereus OsiSh-2 (MDFG00000000), S. sporocinereus NBRC100766 (BCAN00000000), M. oryzae 70-15 (AACU00000000), M. oryzae P131 (AHZT00000000), and M. oryzae Y34 (AHZS00000000)). The COG, KOG, GO, and KEGG pathway analyses showed that only three genes encoding ferric reductase were found in both S. sporocinereus strains OsiSh-2 and NBRC100766 (Fig. 2a). Conversely, the M. oryzae strains 70-15, P131, and Y34 possess noticeably higher numbers, i.e., 21, 18, and 21, respectively. From the protein blasts based on the ferric reductase database that we had constructed, we found that the ferric reductase of S. sporocinereus belonged to two families, FRE and CFL (Fig. 2b). FRE family members commonly reduce the ferric form of iron, while the CFL family members serve as minor rescuers [32, 33]. In contrast, four ferric reductase families, FRE, FET, CFL, and AIM, were found in M. oryzae. We noted that FRE is the main component in the ferric reductases of M. oryzae (average, 71.7%) (Fig. 2b).
Iron uptake system analysis of S. sporocinereus (OsiSh-2 and NBRC 100766) and M. oryzae microbes (70-15, P131, and Y34). a Ferric reductase- and siderophore-related genes in genomes. b Classification of ferric reductase protein families. c Functional classification of siderophore-related genes. d Numbers of peroxidase- and catalase-related genes. Genes related to either peroxidase or catalase are defined as unclassified
In contrast to the situation for ferric reductase, S. sporocinereus possessed nearly threefold siderophore biosynthetic genes and sixfold siderophore-recognizing and siderophore-transporting genes compared to M. oryzae (Fig. 2a, c). As OsiSh-2 possesses a large number of siderophore biosynthetic genes (35), we further estimated whether this siderophore-producing ability of OsiSh-2 is prominent in actinomycetes. The comparison was made among OsiSh-2, 13 actinomycete strains with antifungal activity and 13 endophytic actinomycete strains without a previous report concerning fungal antagonism. As shown in Table 1, all of the antifungal actinomycetes possessed at least one siderophore biosynthetic gene cluster, and five of them (including OsiSh-2) reached the highest number, 4. However, a relatively small amount or even no siderophore biosynthetic gene clusters were found in the compared endophytic actinomycetes. In addition, two of the siderophore biosynthetic gene clusters in OsiSh-2 were 100% similar to those of the siderophores desferrioxamine B and coelichelin, which are commonly found in many Streptomyces species [17, 34, 35]. The other two predicted gene clusters of OsiSh-2 were considered to be nonribosomal peptide synthetase-independent siderophores [36].
In addition, excess iron may cause cytotoxicity by generating an excess of harmful hydroxyl radicals through the Fenton reaction [37]. Since hydrogen peroxide (H2O2) is the substrate of the Fenton reaction, we attempted to assess the H2O2-reducing capacity of S. sporocinereus and M. oryzae through analysis of H2O2 hydrolysis-related genes. The similar number of genes encoding catalase and peroxidase in these two microbes (Fig. 2d) suggested that they may behave similarly to alleviate the adverse effects of hydroxyl radicals [38].
Siderophore Production and Fe3+-Reducing Activity of OsiSh-2 and Guy11 Under Iron-Supplemental and Iron-Starved Conditions
Based on the bioinformatics analysis, we assumed that OsiSh-2 possessed a greater ability than M. oryzae to apply a siderophore system to obtain iron from the environment, while M. oryzae might be more effective at ferric iron reduction. To confirm this hypothesis, we analyzed the siderophore production and Fe3+-reducing activity of OsiSh-2 and Guy11 under different iron concentrations. As a result, OsiSh-2 produced many more extracellular siderophores than Guy11 on both the standard and the iron-starved medium (containing 10 μM 2,2′-dipyridyl) (Fig. 3a, c). However, low additions of FeCl3 (10 μM) considerably reduced siderophore production by both strains (Fig. 3b). It was interesting to note that low additions of FeCl3 could induce the Fe3+-reducing activity of OsiSh-2 more effectively than that of Guy11 (Fig. 3e). To investigate whether higher siderophore production and Fe3+-reducing activities were caused by increases in microbial growth, the growth curves of OsiSh-2 and Guy11 were determined. Both OsiSh-2 and Guy11 thrived under all conditions (with or without FeCl3 or 2,2′-dipyridyl supplementation) (Fig. 3g–i). This finding indicated that the higher production of siderophores and Fe3+-reducing activity in OsiSh-2 than in Guy11 is less related to the growth condition of the cells.
Competition for Iron Resources Between OsiSh-2 and Guy11 Cocultivated on PDA Medium
Based on the above data, we assumed that the advantage of siderophore production of the endophytic OsiSh-2 might help to antagonize the pathogen M. oryzae by competing for limited iron resources in the host plant. To test this hypothesis, we analyzed the iron mobilization between OsiSh-2 and Guy11 cocultivated on PDA media. The plate was equidistantly marked out in seven regions (Fig. 4), and the iron content in each region was measured. Before inoculation, the iron concentration was the same in all the seven regions. However, at the fifth day, when OsiSh-2 and Guy11 were experiencing a rapid growth period, the iron concentration of the media under the colonies of OsiSh-2 (point 6) and Guy11 (point 2) increased. Additionally, there was an apparent decrease in the iron concentration in the samples near OsiSh-2 (points 5, 7) and Guy11 (points 1, 3) (Fig. 4). As expected, the iron was moving from the medium into the accumulating biomass. However, it is worth noting that the iron concentration at point 6 is much higher than that at point 2, indicating that more iron was attracted to OsiSh-2 than to Guy11.
Iron mobilization between OsiSh-2 and Guy11 grown on PDA media for 5 days. Iron concentrations (mg Fe/g sample) in different blocks of media plate, which are defined as points 1, 2 (Guy11 inoculated), 3, 4, 5, 6 (OsiSh-2 inoculated), and 7, are indicated by the heat map. The distance between adjacent points is 1 cm
If the siderophore-mediated iron competition contributes to the antagonistic activity of OsiSh-2, it is likely that the iron-rich condition will decrease the depressive effect due to the fact that fewer siderophores were produced by OsiSh-2. As shown in Fig. 5, the inhibition of Guy11 by OsiSh-2 was indeed weakened when iron (5 μmol FeCl3) was added near OsiSh-2.
Discussion
Iron Requirements of the Pathogen M. oryzae Guy11 and the Rice Endophyte S. sporocinereus OsiSh-2
A large amount of research has verified that iron significantly affects the growth and development of almost all microorganisms [39, 40]. Compared with bacteria, fungi seem to rely more on iron supplementation [40, 41] probably due to the requirement to provide more energy to the eukaryotic biological system. For some fungal pathogens, such as Ustilago maydis and Fusarium oxysporum, their virulence is significantly influenced by iron uptake. These pathogens cause more serious disease on plants grown under an iron-rich environment [42, 43]. In agreement with previous reports, this work revealed that the pathogenic fungus M. oryzae evidently required iron for hyphal expansion and conidiation and that it was not able to survive when the iron supplementation was severely restricted (Fig. 1). In contrast, the endophytic actinomycete OsiSh-2 exhibited stable growth under both iron-sufficient and iron-starved conditions (Fig. 1). This feature might have developed to fit its particular niche, i.e., a close symbiotic relationship with its host plant. Especially under limited iron conditions, the endophyte OsiSh-2 possibly possesses a better survival advantage compared to Guy11. The host plant is a good example of this iron-restricted environment since plants use iron-withholding strategies to defend against pathogens [41]. Based on the results of this work, we assumed that the endophyte OsiSh-2 might exploit the weaknesses of the pathogen M. oryzae for iron dependency. For example, it controls the growth of M. oryzae by competitive iron acquisition. A similar strategy was found in Metschnikowia strains isolated from grapes; these strains inhibited Botrytis cinerea by depleting iron [44].
Iron Uptake Systems Developed in the Rice Endophyte S. sporocinereus and the Fungal Pathogen M. oryzae
Common iron uptake systems in microbes include the siderophore-mediated system [45] and the extracellular Fe3+ reduction and uptake system [45, 46]. Bacteria and fungi may adopt different strategies to obtain iron from the environment.
A high number of siderophore-related genes have been reported in rice endophytes by metagenome research [47]. Similarly, our genomic analysis revealed that the rice endophyte S. sporocinereus OsiSh-2 possesses a much large number of genes responsible for siderophore biosynthesis and uptake than M. oryzae (Fig. 2c). Conversely, more genes encoding for ferric reductase were found in the genomes of M. oryzae than in those of S. sporocinereus (Fig. 2b). These data suggested that M. oryzae and S. sporocinereus may use different models for iron acquisition. S. sporocinereus uses siderophores more frequently, while M. oryzae utilizes more ferric reductase in its iron uptake activities. However, ferric reductase normally converts the iron resource into a more bioavailable format for microorganisms [32] rather than chelating iron. This finding suggested that the endophyte OsiSh-2 might possess an advantage in competing against M. oryzae for iron.
Actinomycetes are well known for their ability to synthesize extracellular enzymes and various antibiotics [48]. Therefore, it is not surprising to find that OsiSh-2 possesses a large number of secondary metabolite biosynthetic gene clusters. Intriguingly, a relatively larger number of siderophore biosynthetic gene clusters was found in antifungal actinomycetes than in common endophytic actinomycetes (Table 1), indicating that the secretion of siderophores might contribute to the antifungal activities of actinomycetes. This finding is consistent with the observation that some endophytes with antagonistic activity against pathogens contain a good ability to produce siderophores [49, 50]. In addition, the existence of siderophore diversity in OsiSh-2 could enhance its competitive advantage for iron acquisition. All these features are in agreement with our previous observation that OsiSh-2 can efficiently inhibit the rice blast in vitro and in vivo [5].
Iron-Capturing Abilities of OsiSh-2 and Guy11
Although siderophore-mediated iron competition has been recognized as one of the antagonistic mechanisms among microbes [37], research directly reflecting a change in the iron concentration surrounding the microbial colonies is rare. In the present study, when the OsiSh-2 and Guy11 were in a dual-cultivation system, the accumulated iron element around the OsiSh-2 colony was much higher than that around the Guy11 colony (Fig. 4). This observation provides evidence for the hypothesis that OsiSh-2 possesses an iron-capturing advantage due to its production of a large amount of siderophores.
Siderophores produced by microorganisms are usually in a reverse correlation with iron concentrations: the production of siderophores is promoted under iron-limited conditions while suppressed under iron-rich conditions [51, 52]. In our study, similar trends of siderophore production were observed for OsiSh-2. In addition, it is worth noting that OsiSh-2 secreted more siderophores than M. oryzae Guy11 under iron-limited conditions (Fig. 3a, c). However, adding a high concentration of iron to OsiSh-2 evidently reduced the inhibition of Guy11 (Fig. 5). These data provided additional evidence for the siderophore-mediated antagonistic action of OsiSh-2 against M. oryzae.
Although bioinformatics analysis indicated that M. oryzae might possess a greater ability to reduce iron, the Fe3+-reducing activity of OsiSh-2 increased noticeably compared to that of M. oryzae Guy11 under iron-supplemental conditions (Fig. 3e). This difference probably occurred because when the iron resource was not restricted, OsiSh-2 used the energy to reduce iron by inducing more iron-reducing enzymes or other related metabolites [24] instead of the biosynthesis of siderophores for iron capture. All these results indicate an advantage of OsiSh-2 in using environmental iron. Moreover, it suggests that an iron-restricted environment in plants is appropriate for the endophyte OsiSh-2 to combat the invasion of M. oryzae.
In addition, the interactions between microbes may involve siderophore piracy, which also plays an important role during iron competition [12, 17]. However, in this study, we did not verify the siderophore piracy between OsiSh-2 and Guy11. Further study on the isolation and purification of the siderophore products of OsiSh-2 is currently underway.
Conclusions
Our work examined endophytic S. sporocinereus OsiSh-2 to research the antagonistic interactions between the endophyte and pathogenic fungi. The crucial role of iron in the development of the pathogen M. oryzae suggested that endophytes might utilize an iron competition strategy to defend against the invasion of the pathogen in the rice host. Comparative bioinformatics analysis and biochemical detection revealed that OsiSh-2 is an excellent siderophore producer, especially in an iron-restricted environment. Two lines of evidence confirmed that siderophores produced by OsiSh-2 contribute to its inhibition of M. oryzae through depriving the fungus of iron: a much larger amount of iron migrated to OsiSh-2 than to M. oryzae in dual culture, and when excess iron was introduced into the inhibition zone near OsiSh-2, the antagonism of OsiSh-2 was decreased. To our knowledge, this is the first report of the role of iron competition in the antagonistic action of an endophyte against M. oryzae. This discovery is valuable for designing new crop protection strategies.
References
Wilson RA, Talbot NJ (2009) Under pressure: investigating the biology of plant infection by Magnaporthe oryzae. Nat Rev Microbiol 7(3):185–195
Ebbole DJ (2007) Magnaporthe as a model for understanding host-pathogen interactions. Annu. Rev. Phytopathol. 45(1):437–456
Miah G, Rafii M, Ismail M, Puteh A, Rahim H, Asfaliza R, Latif M (2013) Blast resistance in rice: a review of conventional breeding to molecular approaches. Mol. Biol. Rep. 40(3):2369–2388
Gnanamanickam SS (2009) Biological control of rice diseases. Springer, Dordrecht, Netherlands
Xu T, Li Y, Zeng X, Yang X, Yang Y, Yuan S, Hu X, Zeng J, Wang Z, Liu Q (2017) Isolation and evaluation of endophytic Streptomyces endus OsiSh-2 with potential application for biocontrol of rice blast disease. J. Sci. Food Agric. 97(4):1149–1157
Araujo R, Kaewkla O, Franco CM (2017) Endophytic actinobacteria: beneficial partners for sustainable agriculture. Endophytes: Biology and Biotechnology
Su Z, Mao L, Li N, Feng X, Yuan Z, Wang L, Lin F, Zhang C (2013) Evidence for biotrophic lifestyle and biocontrol potential of dark septate endophyte Harpophora oryzae to rice blast disease. PLoS One 8(4):e61332
Keerthana U, Nagendran K, Raguchander T, Prabakar K, Rajendran L, Karthikeyan G (2017) Deciphering the role of Bacillus subtilis var. amyloliquefaciens in the management of late blight pathogen of potato, Phytophthora infestans. P Natl A Sci India B 2017:1–10
Dutta D, Puzari KC, Gogoi R, Dutta P (2014) Endophytes: exploitation as a tool in plant protection. Braz Arch Biol Techn 57(5):621–629
El-Tarabily K, Nassar A, Hardy GSJ, Sivasithamparam K (2009) Plant growth promotion and biological control of Pythium aphanidermatum, a pathogen of cucumber, by endophytic actinomycetes. J. Appl. Microbiol. 106(1):13–26
Cao L, Qiu Z, You J, Tan H, Zhou S (2005) Isolation and characterization of endophytic streptomycete antagonists of fusarium wilt pathogen from surface-sterilized banana roots. FEMS Microbiol. Lett. 247(2):147–152
Arias AA, Lambert S, Martinet L, Adam D, Tenconi E, Hayette M-P, Ongena M, Rigali S (2015) Growth of desferrioxamine-deficient Streptomyces mutants through xenosiderophore piracy of airborne fungal contaminations. FEMS Microbiol. Ecol. 91(7):1–9
Schaible UE, Kaufmann SH (2004) Iron and microbial infection. Nat Rev Microbiol 2(12):946–953
Haas H, Eisendle M, Turgeon BG (2008) Siderophores in fungal physiology and virulence. Annu. Rev. Phytopathol. 46:149–187
Loper JE, Henkels MD (1999) Utilization of heterologous siderophores enhances levels of iron available to Pseudomonas putida in the rhizosphere. Appl Environ Microb 65(12):5357–5363
O'sullivan DJ, O'Gara F (1992) Traits of fluorescent Pseudomonas spp. involved in suppression of plant root pathogens. Microbiol. Rev. 56(4):662–676
Traxler MF, Seyedsayamdost MR, Clardy J, Kolter R (2012) Interspecies modulation of bacterial development through iron competition and siderophore piracy. Mol. Microbiol. 86(3):628–644
Loper JE, Buyer JS (1991) Siderophores in microbial interactions on plant surfaces. Mol Plant Microbe In 4(1):5–13
Askwith C, Kaplan J (1997) An oxidase-permease-based iron transport system in Schizosaccharomyces pombe and its expression in Saccharomyces cerevisiae. J. Biol. Chem. 272(1):401–405
Homuth M, Valentin-Weigand P, Rohde M, Gerlach G-F (1998) Identification and characterization of a novel extracellular ferric reductase from Mycobacterium paratuberculosis. Infect. Immun. 66(2):710–716
Li J, Chi Z, Li H, Wang X (2008) Characterization of a mutant of Alteromonas aurantia A18 and its application in mariculture. J Ocean U China 7(1):55–59
Tierrafría VH, Ramos-Aboites HE, Gosset G, Barona-Gómez F (2011) Disruption of the siderophore-binding desE receptor gene in Streptomyces coelicolor A3 (2) results in impaired growth in spite of multiple iron-siderophore transport systems. Microb. Biotechnol. 4(2):275–285
Schwyn B, Neilands J (1987) Universal chemical assay for the detection and determination of siderophores. Anal. Biochem. 160(1):47–56
Ma J, Zhang K, Huang M, Hector SB, Liu B, Tong C, Liu Q, Zeng J, Gao Y, Xu T (2016) Involvement of Fenton chemistry in rice straw degradation by the lignocellulolytic bacterium Pantoea ananatis Sd-1. Biotechnol Biofuels 9(1):211
Wu S, Zhu Z, Fu L, Niu B, Li W (2011) WebMGA: a customizable web server for fast metagenomic sequence analysis. BMC Genomics 12(1):444
McCarthy FM, Wang N, Magee GB, Nanduri B, Lawrence ML, Camon EB, Barrell DG, Hill DP, Dolan ME, Williams WP (2006) AgBase: a functional genomics resource for agriculture. BMC Genomics 7(1):229
Weber T, Blin K, Duddela S, Krug D, Kim HU, Bruccoleri R, Lee SY, Fischbach MA, Müller R, Wohlleben W (2015) antiSMASH 3.0—a comprehensive resource for the genome mining of biosynthetic gene clusters. Nucleic Acids Res. 43(W1):W237–W243
Grijseels S, Nielsen JC, Randelovic M, Nielsen J, Nielsen KF, Workman M, Frisvad JC (2016) Penicillium arizonense, a new, genome sequenced fungal species, reveals a high chemical diversity in secreted metabolites. Sci. Rep. 6:3511
Tamura H, Goto K, Yotsuyanagi T, Nagayama M (1974) Spectrophotometric determination of iron (II) with 1, 10-phenanthroline in the presence of large amounts of iron (III). Talanta 21(4):314–318
Barnett N (1970) Dipyridyl-induced cell elongation and inhibition of cell wall hydroxyproline biosynthesis. Plant Physiol. 45(2):188–191
DeKock P, Vaughan D (1975) Effects of some chelating and phenolic substances on the growth of excised pea root segments. Planta 126(2):187–195
Schröder I, Johnson E, de Vries S (2003) Microbial ferric iron reductases. FEMS Microbiol. Rev. 27(2–3):427–447
Hammacott JE, Williams PH, Cashmore AM (2000) Candida albicans CFL1 encodes a functional ferric reductase activity that can rescue a Saccharomyces cerevisiae fre1 mutant. Microbiology 146(4):869–876
Lautru S, Deeth RJ, Bailey LM, Challis GL (2005) Discovery of a new peptide natural product by Streptomyces coelicolor genome mining. Nat. Chem. Biol. 1(5):265–269
Barona-Gomez F, Lautru S, Francou F, Leblond P, Pernodet J, Challis GL (2006) Multiple biosynthetic and uptake systems mediate siderophore-dependent iron acquisition in Streptomyces coelicolor A3 (2) and Streptomyces ambofaciens ATCC 23877. Microbiology 152(11):3355–3366
Challis GL (2005) A widely distributed bacterial pathway for siderophore biosynthesis independent of nonribosomal peptide synthetases. Chembiochem 6(4):601–611
Verbon EH, Trapet PL, Stringlis IA, Kruijs S, Bakker PA, Pieterse CM (2017) Iron and immunity. Annu. Rev. Phytopathol. 55(1):355–375
Mao GD, Thomas P, Lopaschuk G, Poznansky M (1993) Superoxide dismutase (SOD)-catalase conjugates. Role of hydrogen peroxide and the Fenton reaction in SOD toxicity. J. Biol. Chem. 268(1):416–420
Bruyneel B, Vande Woestyne M, Verstraete W (1989) Lactic acid bacteria: micro-organisms able to grow in the absence of available iron and copper. Biotechnol. Lett. 11(6):401–406
Philpott CC, Leidgens S, Frey AG (2012) Metabolic remodeling in iron-deficient fungi. Biochim. Biophys. Acta 1823(9):1509–1520
Comensoli L, Bindschedler S, Junier P, Joseph E (2017) Chapter two—iron and fungal physiology: a review of biotechnological opportunities. Adv. Appl. Microbiol. 98:31–60
Eichhorn H, Lessing F, Winterberg B, Schirawski J, Kämper J, Müller P, Kahmann R (2006) A ferroxidation/permeation iron uptake system is required for virulence in Ustilago maydis. Plant Cell 18(11):3332–3345
Simeoni LA, Lindsay W, Baker R (1987) Critical iron level associated with biological control of Fusarium wilt. Phytopathology 77(6):1057–1061
Sipiczki M (2006) Metschnikowia strains isolated from botrytized grapes antagonize fungal and bacterial growth by iron depletion. Appl. Environ. Microbiol. 72(10):6716–6724
Cornelis P, Dingemans J (2013) Pseudomonas aeruginosa adapts its iron uptake strategies in function of the type of infections. Front. Cell. Infect. Microbiol. 3(3):75
Brown JS, Holden DW (2002) Iron acquisition by Gram-positive bacterial pathogens. Microbes Infect. 4(11):1149–1156
Sessitsch A, Hardoim P, Döring J, Weilharter A, Krause A, Woyke T, Mitter B, Hauberg-Lotte L, Friedrich F, Rahalkar M (2012) Functional characteristics of an endophyte community colonizing rice roots as revealed by metagenomic analysis. Mol. Plant-Microbe Interact. 25(1):28–36
Newman DJ, Cragg GM (2007) Natural products as sources of new drugs over the last 25 years. J. Nat. Prod. 70(3):461–477
Berg G, Krechel A, Ditz M, Sikora RA, Ulrich A, Hallmann J (2005) Endophytic and ectophytic potato-associated bacterial communities differ in structure and antagonistic function against plant pathogenic fungi. FEMS Microbiol. Ecol. 51(2):215–229
Li C, Zhao M, Tang C, Li S (2010) Population dynamics and identification of endophytic bacteria antagonistic toward plant-pathogenic fungi in cotton root. Microb. Ecol. 59(2):344–356
Rachid D, Ahmed B (2005) Effect of iron and growth inhibitors on siderophores production by Pseudomonas fluorescens. Afr. J. Biotechnol. 4(7):697–702
Manninen M, Mattila-Sandholm T (1994) Methods for the detection of Pseudomonas siderophores. J Microbiol Meth 19(3):223–234
Funding
This work is financially supported by the National Natural Science Foundation of China (31672093).
Author information
Authors and Affiliations
Corresponding author
Electronic supplementary material
Table S1
(DOCX 13 kb)
Rights and permissions
About this article
Cite this article
Zeng, J., Xu, T., Cao, L. et al. The Role of Iron Competition in the Antagonistic Action of the Rice Endophyte Streptomyces sporocinereus OsiSh-2 Against the Pathogen Magnaporthe oryzae. Microb Ecol 76, 1021–1029 (2018). https://doi.org/10.1007/s00248-018-1189-x
Received:
Accepted:
Published:
Issue Date:
DOI: https://doi.org/10.1007/s00248-018-1189-x